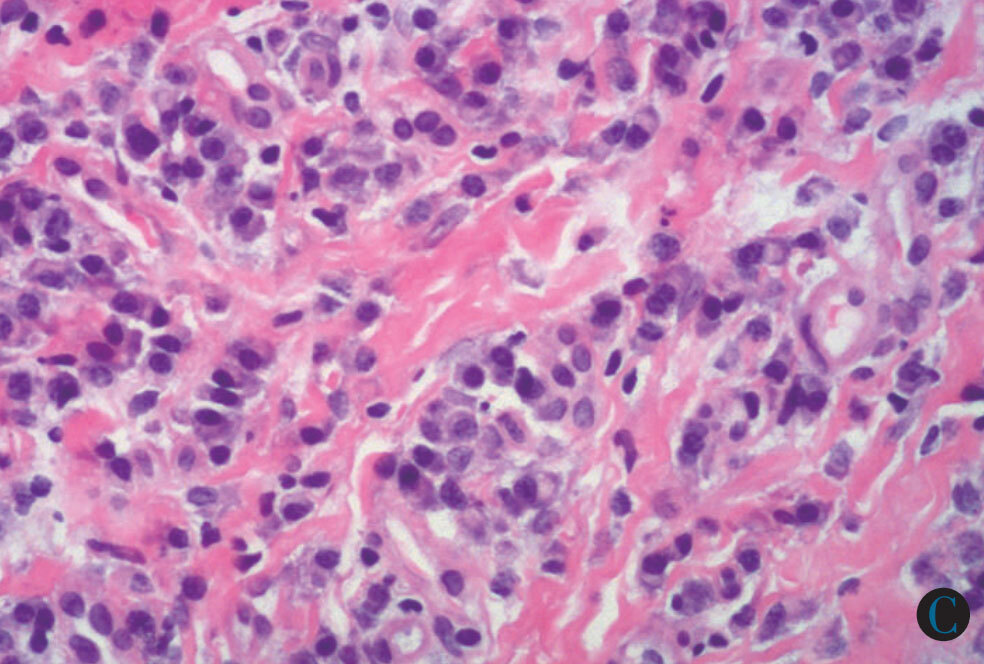
得了「浆细胞性包皮龟头炎」别着急,看这文章就清楚了 - 好大夫在线

各种炎细胞

炎性细胞
图片尺寸640x481
炎细胞
图片尺寸1080x1441
炎性细胞
图片尺寸640x465
红细胞 2.嗜酸性粒细胞 3.嗜碱性粒细胞 4.中性粒细胞 5.淋巴细胞 6.
图片尺寸1080x810
请教怎么看病理图中的炎性细胞非常感谢
图片尺寸900x419
炎细胞
图片尺寸581x1032
炎症,光镜下显示不同的炎症细胞
图片尺寸1200x800
炎性细胞
图片尺寸640x480
各种炎细胞
图片尺寸1080x810
炎症病变中,主要有中性粒细胞和巨噬细胞两种吞噬细胞,其中巨噬细胞
图片尺寸267x393
炎症ppt 病理学课件 免疫作用 淋巴细胞和浆细胞: 体液免疫和细胞免疫
图片尺寸1080x810
感染性心内膜炎ppt
图片尺寸1080x810
得了「浆细胞性包皮龟头炎」别着急,看这文章就清楚了 - 好大夫在线
图片尺寸984x664
炎症因子化学和细胞因子参与炎症的响应照片
图片尺寸296x300
大量炎症细胞的背景下,可见散在的尿路上皮细胞,有的细胞表面覆盖大量
图片尺寸661x496
关于炎症细胞的描述,下列哪项不正确()
图片尺寸456x339
段师教学系列第2期慢性非特异性炎症反应细胞学特征
图片尺寸750x348
炎细胞渗出
图片尺寸504x330
大量炎症细胞的背景下,可见散在的尿路上皮细胞,有的细胞表面覆盖大量
图片尺寸661x496
食管炎症性病变诊断浅析_细胞
图片尺寸1080x813